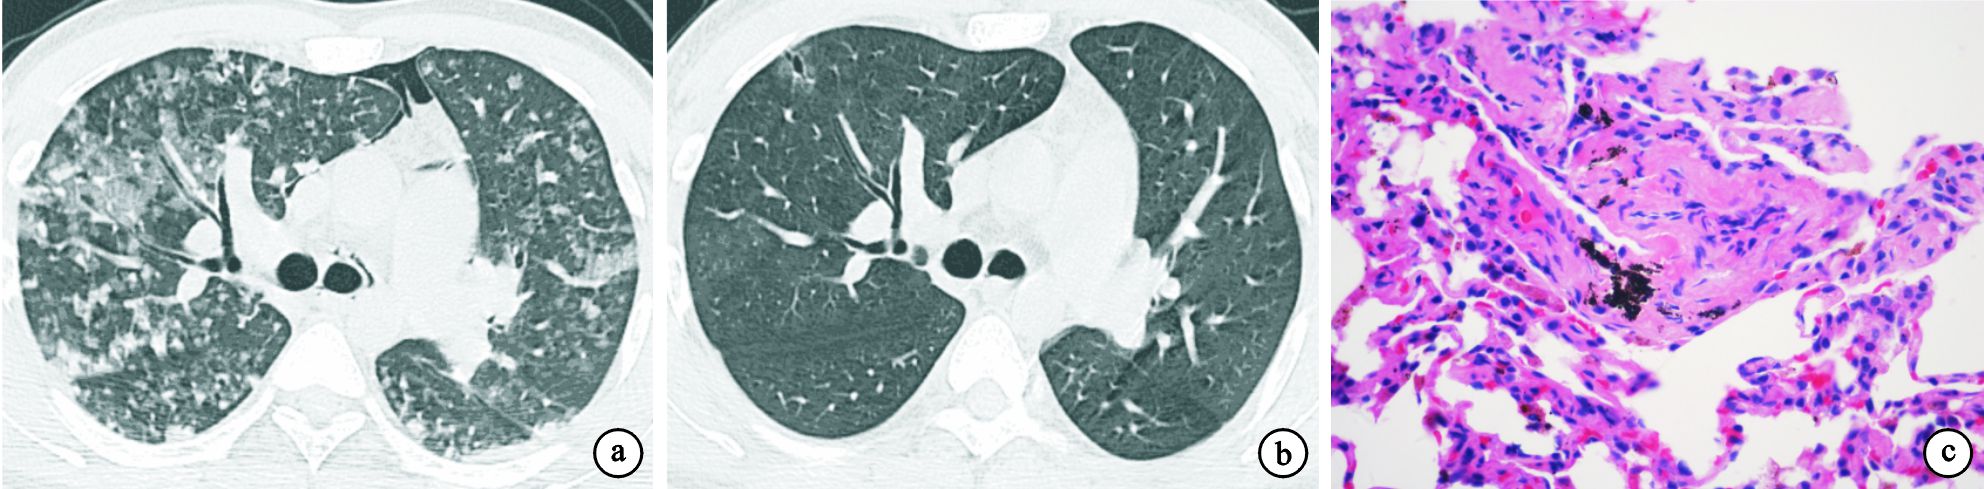

引用本文: 邱玉英, 陳露露, 王永生, 陳慧芬, 蔡后榮, 肖永龍, 葉慶, 孟凡青, 馮安寧. 24例過敏性肺炎的臨床、影像學及病理分析. 中國呼吸與危重監護雜志, 2014, 13(1): 38-43. doi: 10.7507/1671-6205.2014010 復制
過敏性肺炎(hypersensitivity pneumonitis,HP),也稱外源性過敏性肺泡炎(extrinsic allergic alveolitis,EAA),是一組由于個體反復吸入外界某些具有抗原性的有機粉塵后所引起的變態反應性肺部炎癥,以間質性肺炎、淋巴細胞性細支氣管炎和肉芽腫為病理特征。HP代表一組疾病,原因各異,但發病機制、病理、臨床表現、影像學、治療和預后相似,故亦可稱之為癥狀群[1]。由于HP的臨床表現多樣,且未被廣泛認識和引起足夠的重視,導致臨床診斷的HP遠低于實際的HP,這種現象在我國尤為明顯。HP的診斷要結合病史、影像學及病理。為了提高對HP的認識,我們收集了南京大學醫學院附屬鼓樓醫院2005年2月至2013年2月診治的24例HP患者的臨床資料,對其臨床和胸部高分辨率CT(HRCT)及病理特征進行回顧性分析,以期提高臨床醫生對該病的認識。
對象與方法
一 對象
2005年2月至2013年2月在南京大學醫學院附屬鼓樓醫院住院并符合入選標準的HP患者24例,男15例,女9例;年齡26~72歲,平均(48±13)歲。24例均有明確的環境暴露史,間歇或持續抗原暴露時間為2個月至15年。寵物飼養或嗜好者16例(養鴿子者7例,養鸚鵡、雞、貓、狗者各3例、3例、2例、1例),接觸化學有機物者2例(油漆、鎳煙霧各l例),使用藥物2例,嗜熱放線菌感染2例,真菌感染1例,蘑菇種植l例。其中吸煙者2例(8.3%)。
入選標準:(1)符合HP的診斷標準;(2)除外其他已知或未知原因間質性肺疾病;(3)有完整的HRCT影像學資料或記錄;(4)有支氣管肺泡灌洗液(BALF)或經支氣管鏡肺活檢(TBLB)資料。
HP的診斷標準[1]:(1)有明確的環境抗原暴露史;(2)有HP相應的臨床征象(咳嗽、呼吸困難、發熱等)或脫離環境抗原暴露后病情改善;(3)胸部影像學檢查提示間質性肺疾病表現(雙肺彌漫性磨玻璃影、斑片影、小葉中心性結節影、馬賽克征、網格影或伴蜂窩肺);(4)肺功能檢查提示限制性肺通氣功能障礙和彌散功能障礙;(5)BALF檢查提示淋巴細胞增高和/或組織病理學檢查提示非壞死性肉芽腫、淋巴濾泡性細支氣管炎以及間質性肺炎等,同時除外結節病、結締組織病繼發的肺間質改變、特發性肺纖維化(IPF)等疾病。
HP的表現形式:按照其臨床表現可分為急性、亞急性及慢性3種形式[1-3]。(1)急性期:指接觸抗原后4~48 h出現畏寒、發熱、不適、咳嗽、呼吸困難等癥狀,間歇、反復發作,脫離接觸或經治療后數周內陰影吸收。胸部HRCT表現為雙肺野可見粟粒樣或腺泡狀、邊緣模糊的小結節影,可有磨玻璃影,或表現為大小不等片狀浸潤影,類似肺水腫。(2)亞急性期:指持續接觸抗原4個月內反復急性發作,出現進行性的呼吸困難,伴咳嗽。胸部HRCT表現為雙肺野線狀、細網狀和結節型改變,可與磨玻璃樣影同時存在。在彌漫的網結節或磨玻璃陰影中有囊性透光區,或有馬賽克征(氣體陷閉),這是因過敏性肺炎伴閉塞性細支氣管炎所致,這是HP的特征之一。(3)慢性期:指暴露于低濃度抗原超過4個月甚至數年后出現隱匿或慢性發展的活動性呼吸困難伴咳嗽、咯痰,可伴有散在吸氣時爆裂音、杵狀指,甚至肺心病體征。胸部HRCT表現為雙肺野廣泛分布的網狀影、蜂窩肺,可見牽拉性細支氣管擴張,肺結構破壞,與IPF類似,病變通常上葉更為嚴重。
二 方法
對24例患者的病歷資料進行回顧性分析。主要記錄項目:(1)臨床癥狀、體征、治療與轉歸情況;(2)胸部HRCT特征,包括磨玻璃影、實變影、小葉中心性結節影、馬賽克征、網格影、蜂窩肺、細支氣管擴張等出現與否及其分布特點;(3)BALF細胞分析或TBLB病理特征,包括非干酪樣壞死性肉芽腫、間質纖維組織增生、細支氣管炎等。
結果
一 臨床特征
24例患者中急性2例,亞急性17例,慢性5例。主要癥狀為咳嗽(14例,58.3%)、呼吸困難(21例,87.5%)、咯痰(10例,41.7%)、發熱(3例,12.5%)和體重減輕(2例,8.3%)。發熱主要見于急性或亞急性患者,多為低、中等度發熱;體重減輕主要見于慢性患者。吸煙者2例(8.3%)。主要陽性體征為輕度發紺(3例,12.5%)、肺部濕啰音或爆裂音(4例,16.7%)和杵狀指(2例,8.3%),主要見于慢性患者。肺功能檢查顯示22例(91.7%)彌散功能障礙,18例(75.0%)限制性通氣功能障礙,19例(79.2%)小氣道功能障礙。血氣分析顯示20例(83.3%)低氧血癥或Ⅰ型呼吸衰竭。急性期2例明確診斷后,避免環境抗原進一步暴露,予甲基潑尼松龍40 mg/d靜滴、氧療和對癥支持治療,病情明顯好轉,后改為潑尼松20 mg/d并逐漸減量,3周內肺部病變基本吸收。17例亞急性患者均伴明顯的肺部滲出和低氧血癥或呼吸衰竭,明確診斷后除避免環境抗原進一步暴露,酌情予以氧療和對癥支持治療外,給予潑尼松40 mg/d,病情緩解后逐漸減量,療程3~6個月。肺部影像學改變基本吸收,病情未再反復。5例慢性患者中2例使用潑尼松40 mg/d治療,癥狀部分緩解,逐漸減量,療程6~12個月,2例長期口服潑尼松10~15 mg/d維持,病情相對穩定。1例慢性患者急性加重死亡。
二 胸部HRCT特征
24例患者的主要胸部HRCT特征總結見表 1。17例(70.8%)雙肺彌漫分布磨玻璃影,多呈斑片或片狀;15例(62.5%)雙肺彌漫分布細支氣管或小葉中心結節,邊緣模糊;10例(41.7%)氣體陷閉或馬賽克征;5例(20.8%)有網格影或伴蜂窩肺。上述改變常重疊存在,磨玻璃影伴馬賽克征10例,小葉中心結節影伴馬賽克征9例,磨玻璃影、小葉中心結節伴馬賽克征7例,彌漫磨玻璃影伴實變影4例,網格影或伴蜂窩肺伴磨玻璃影2例。2例急性患者分別表現為彌漫磨玻璃影伴實變影(圖 1a、圖 2a),脫離暴露因素并給予甲基潑尼松龍靜滴,后改為潑尼松治療后,3周內病變明顯吸收(圖 1b、圖 2b)。17例亞急性患者中14例(82.4%)為彌漫分布的小葉中心結節(圖 3a、圖 4a),3例(76.5%)為磨玻璃影,8例(47.1%)為馬賽克征,8例(47.1%)為彌漫分布的斑片磨玻璃影伴馬賽克征。脫離暴露因素并給予潑尼松治療后病變均明顯吸收(圖 3b、圖 4b)。5例慢性患者均表現為網格影或伴蜂窩肺(圖 5a),其中2例伴斑片磨玻璃影,1例伴馬賽克征,1例伴小葉中心結節。

三 病理特征
急性期2例行TBLB檢查,病理為肺泡壁和細支氣管壁水腫,以淋巴細胞性肺泡和間質炎癥為主,而嗜酸粒細胞浸潤較少。肺泡腔內有蛋白滲出及炎癥細胞(圖 1c、圖 2c)。亞急性期17例均行TBLB病理檢查,其中11例間質中見非干酪性壞死肉芽腫(圖 3c),其對應的HRCT表現為典型的小葉中心結節,另6例見單核細胞浸潤所致的細支氣管炎(圖 4c)。慢性期5例中有1例開胸肺活檢,病理見纖維化及成纖維細胞灶(圖 5c),其對應的HRCT表現為網格影伴蜂窩肺或牽拉性支氣管擴張(圖 5a)。1例因急性加重死亡,其余3例行BALF檢查。22例(2例急性,17例亞急性,3例慢性)BALF檢查提示肺泡淋巴細胞滲出為主的炎癥,巨噬細胞(31.5±18.3)%,淋巴細胞(36.4±19.7)%,中性粒細胞(22.4±18.5)%,嗜酸粒細胞中位數為2.3%(0.5%~4.5%)。CD4/CD8 T淋巴細胞比值中位數為0.96(0.48~1.61)。





討論
HP多為在工作場所吸入植物或動物的有機粉塵所引起。有機粉塵顆粒通常小于5 μm,反應原進入小氣道和肺泡并進入周圍肺組織,引起肺組織強烈免疫反應和炎癥。目前已經證明可引起HP的抗原物質有200余種,常見的有放線菌、真菌孢子、動植物蛋白質和某些低分子化學物質等。因接觸的抗原的條件和來源不同,本病可有多種不同的疾病名稱,如吸入含嗜熱放線菌(主要為微小多孢子菌,其次為普通嗜熱放線菌)的霉干草粉塵引起的過敏性肺炎稱農民肺(farmer’s lung),吸入含動物蛋白羽毛和排泄物的塵埃引起者稱飼鳥者肺(bird breeder lung),吸入含嗜熱放線菌的蘑菇肥料引起者稱蘑菇工人肺(mushroom worker disease),生活在有嗜熱放線菌污染的空調或濕化器環境引起者稱空調器肺(air conditioner lung)或濕化器肺(humidifier lung)等。
本組24例HP患者均有明確的環境暴露因素,主要暴露因素是寵物飼養或嗜好,以鴿子飼養或嗜好者多見,同時也有其他寵物如鸚鵡、雞、貓、狗飼養或嗜好者,說明寵物嗜好或家庭環境暴露引起的HP是不可忽視的健康問題。此外,化學有機物、藥物、蘑菇種植、真菌孢子也是HP常見的誘因。HP的臨床表現與吸入抗原的量及暴露時間有關,根據初始臨床表現及病程分為急性、亞急性和慢性。急性和亞急性之間存在一定重疊。雖然急性形式是最常見和最具特征的表現形式,但是多數患者癥狀輕微,脫離抗原暴露后自行緩解,很少被診斷。因此,臨床診斷的HP以亞急性和慢性形式為多。本組病例中僅2例表現為急性,絕大多數患者表現為亞急性或慢性。
HP的發病機制尚不完全清楚。目前認為HP最初由Ⅲ型變態反應介導,而后轉向Ⅳ型變態反應為主,而巨噬細胞激活及由此產生的炎癥反應則又可以通過非免疫途徑共同引起肺損傷。此外,接觸有機粉塵的人群中只有少數人發生HP,提示發病者有易感性存在,可能與人類白細胞抗原(HLA)有關,HLA可能是決定遺傳免疫反應的因素,在本病發病中起一定作用。有人認為單獨的侵入抗原可能并不足以引起HP,往往同時存在促發因素,如病毒感染可能導致肺泡巨噬細胞功能改變而促使HP的發生。此外,80%~95%的HP病例發生在非吸煙者,本組吸煙者僅為8.3%,可能與吸煙的免疫抑制效應有關,但吸煙者預后較差,從側面說明吸煙不是罹患HP的危險因素[4-5]。
HP的臨床表現差異較大,取決于接觸抗原的多少、頻繁程度和接觸時間的長短以及宿主的反應性等,可分為急性,亞急性及慢性三種。臨床常見的癥狀為咳嗽、呼吸困難、咳痰、低熱、體重減輕等,而本組最常見的癥狀為呼吸困難。最常見的體征為肺部濕啰音或爆裂音、喘鳴音、輕度發紺、杵狀指等。本組肺功能檢查顯示患者幾乎均有彌散功能障礙,其中大部分有限制性通氣功能障礙和小氣道功能障礙,與文獻報道一致[6]。血氣分析也顯示大部分有低氧血癥或Ⅰ型呼吸衰竭。
本組HP患者胸部HRCT的主要特征為磨玻璃影、小葉中心結節、馬賽克征、網格影或蜂窩肺,與文獻報道一致[6-11]。這些HRCT改變在不同臨床表現形式的出現頻率不同,而且經常是幾種表現同時出現。急性主要表現為彌漫磨玻璃影伴實變影;亞急性主要表現為雙肺彌漫分布的小葉中心結節、馬賽克征和斑片磨玻璃影伴馬賽克征;慢性主要表現網格影或伴蜂窩肺,小葉間隔增厚或牽拉性細支氣管擴張。這些特征與HP的不同臨床表現形式有關,掌握這些特點對于HP的診斷有重要幫助。據胸部HRCT的特征,結合環境抗原暴露史、相應的臨床表現、BALF提示淋巴細胞為主的肺部滲出及TBLB病理,通常可以做出診斷。僅少部分慢性HP患者由于TBLB所取的肺組織不能代表全肺的病變情況,需要外科肺活檢行病理檢查幫助確定診斷。
HP雖然病原很多,但在組織學上的改變非常近似,多數不能從組織形態學上鑒別,病理學特征取決于抗原暴露的程度及活檢時病程所處的階段。急性期病理表現為肺泡壁和細支氣管壁水腫,以淋巴細胞性肺泡和間質炎癥為主,肺泡腔內有蛋白滲出及炎癥細胞。亞急性期的特征性改變是非干酪樣壞死性肉芽腫形成,和/或單核細胞浸潤所致的細支氣管炎。肺肉芽腫常在發病3周內出現,在1年內緩慢消散,用糖皮質激素可促進其吸收。慢性期以肺間質纖維化為主,尤其在細支氣管和所屬小動脈有時因肌纖維和內皮細胞增生而增厚,而肉芽腫病變此時基本消失。由于纖維化的牽拉和收縮,肺組織結構破壞,可發展為肺氣腫乃至蜂窩肺。本組急性及亞急性HP均行TBLB病理檢查,一部分見非壞死性肉芽腫,一部分為淋巴細胞性細支氣管炎,基本得以病理診斷,這與我們TBLB所取的肺組織大部分在0.2 cm以上且為多部位獲取組織有關。患者BALF細胞學檢查均顯示淋巴細胞明顯增加。本組慢性HP患者的診斷主要依據相關抗原的暴露、影像學、BALF的細胞學改變。對于胸部HRCT顯示的網格影或伴蜂窩肺或牽拉性細支氣管擴張的患者,TBLB的病理診斷意義有限,最好行外科肺活檢。但本組5例慢性HP患者除1例急性加重死亡外,1例行外科肺活檢,其余3例行BALF檢查。文獻報道慢性HP組織學顯示UIP樣改變或纖維化型NSIP樣改變的HP起病隱匿,預后差,而組織學呈閉塞性細支氣管炎伴機化性肺炎或細胞型NSIP樣改變的HP多易反復發作,但預后好[12-13]。胸部HRCT特征在一定程度上可以間接反映HP的組織病理類型,可能對預后有一定的提示作用。
綜上所述,臨床上HP是少見病,診斷困難,經常漏診或誤診,造成病情遷延不愈,呈慢性化發展而影響預后。對于急性及亞急性HP病例,我們應根據其臨床特征,包括相關抗原的暴露、影像學、BALF的細胞學改變及TBLB病理作出診斷。對于慢性的HP病例,尤其是暴露因素不典型時,要有足夠的識別能力,TBLB所取的組織不足以代表全肺的病變狀態,必要時進行外科肺活檢而做出臨床-影像學-病理的綜合診斷。
過敏性肺炎(hypersensitivity pneumonitis,HP),也稱外源性過敏性肺泡炎(extrinsic allergic alveolitis,EAA),是一組由于個體反復吸入外界某些具有抗原性的有機粉塵后所引起的變態反應性肺部炎癥,以間質性肺炎、淋巴細胞性細支氣管炎和肉芽腫為病理特征。HP代表一組疾病,原因各異,但發病機制、病理、臨床表現、影像學、治療和預后相似,故亦可稱之為癥狀群[1]。由于HP的臨床表現多樣,且未被廣泛認識和引起足夠的重視,導致臨床診斷的HP遠低于實際的HP,這種現象在我國尤為明顯。HP的診斷要結合病史、影像學及病理。為了提高對HP的認識,我們收集了南京大學醫學院附屬鼓樓醫院2005年2月至2013年2月診治的24例HP患者的臨床資料,對其臨床和胸部高分辨率CT(HRCT)及病理特征進行回顧性分析,以期提高臨床醫生對該病的認識。
對象與方法
一 對象
2005年2月至2013年2月在南京大學醫學院附屬鼓樓醫院住院并符合入選標準的HP患者24例,男15例,女9例;年齡26~72歲,平均(48±13)歲。24例均有明確的環境暴露史,間歇或持續抗原暴露時間為2個月至15年。寵物飼養或嗜好者16例(養鴿子者7例,養鸚鵡、雞、貓、狗者各3例、3例、2例、1例),接觸化學有機物者2例(油漆、鎳煙霧各l例),使用藥物2例,嗜熱放線菌感染2例,真菌感染1例,蘑菇種植l例。其中吸煙者2例(8.3%)。
入選標準:(1)符合HP的診斷標準;(2)除外其他已知或未知原因間質性肺疾病;(3)有完整的HRCT影像學資料或記錄;(4)有支氣管肺泡灌洗液(BALF)或經支氣管鏡肺活檢(TBLB)資料。
HP的診斷標準[1]:(1)有明確的環境抗原暴露史;(2)有HP相應的臨床征象(咳嗽、呼吸困難、發熱等)或脫離環境抗原暴露后病情改善;(3)胸部影像學檢查提示間質性肺疾病表現(雙肺彌漫性磨玻璃影、斑片影、小葉中心性結節影、馬賽克征、網格影或伴蜂窩肺);(4)肺功能檢查提示限制性肺通氣功能障礙和彌散功能障礙;(5)BALF檢查提示淋巴細胞增高和/或組織病理學檢查提示非壞死性肉芽腫、淋巴濾泡性細支氣管炎以及間質性肺炎等,同時除外結節病、結締組織病繼發的肺間質改變、特發性肺纖維化(IPF)等疾病。
HP的表現形式:按照其臨床表現可分為急性、亞急性及慢性3種形式[1-3]。(1)急性期:指接觸抗原后4~48 h出現畏寒、發熱、不適、咳嗽、呼吸困難等癥狀,間歇、反復發作,脫離接觸或經治療后數周內陰影吸收。胸部HRCT表現為雙肺野可見粟粒樣或腺泡狀、邊緣模糊的小結節影,可有磨玻璃影,或表現為大小不等片狀浸潤影,類似肺水腫。(2)亞急性期:指持續接觸抗原4個月內反復急性發作,出現進行性的呼吸困難,伴咳嗽。胸部HRCT表現為雙肺野線狀、細網狀和結節型改變,可與磨玻璃樣影同時存在。在彌漫的網結節或磨玻璃陰影中有囊性透光區,或有馬賽克征(氣體陷閉),這是因過敏性肺炎伴閉塞性細支氣管炎所致,這是HP的特征之一。(3)慢性期:指暴露于低濃度抗原超過4個月甚至數年后出現隱匿或慢性發展的活動性呼吸困難伴咳嗽、咯痰,可伴有散在吸氣時爆裂音、杵狀指,甚至肺心病體征。胸部HRCT表現為雙肺野廣泛分布的網狀影、蜂窩肺,可見牽拉性細支氣管擴張,肺結構破壞,與IPF類似,病變通常上葉更為嚴重。
二 方法
對24例患者的病歷資料進行回顧性分析。主要記錄項目:(1)臨床癥狀、體征、治療與轉歸情況;(2)胸部HRCT特征,包括磨玻璃影、實變影、小葉中心性結節影、馬賽克征、網格影、蜂窩肺、細支氣管擴張等出現與否及其分布特點;(3)BALF細胞分析或TBLB病理特征,包括非干酪樣壞死性肉芽腫、間質纖維組織增生、細支氣管炎等。
結果
一 臨床特征
24例患者中急性2例,亞急性17例,慢性5例。主要癥狀為咳嗽(14例,58.3%)、呼吸困難(21例,87.5%)、咯痰(10例,41.7%)、發熱(3例,12.5%)和體重減輕(2例,8.3%)。發熱主要見于急性或亞急性患者,多為低、中等度發熱;體重減輕主要見于慢性患者。吸煙者2例(8.3%)。主要陽性體征為輕度發紺(3例,12.5%)、肺部濕啰音或爆裂音(4例,16.7%)和杵狀指(2例,8.3%),主要見于慢性患者。肺功能檢查顯示22例(91.7%)彌散功能障礙,18例(75.0%)限制性通氣功能障礙,19例(79.2%)小氣道功能障礙。血氣分析顯示20例(83.3%)低氧血癥或Ⅰ型呼吸衰竭。急性期2例明確診斷后,避免環境抗原進一步暴露,予甲基潑尼松龍40 mg/d靜滴、氧療和對癥支持治療,病情明顯好轉,后改為潑尼松20 mg/d并逐漸減量,3周內肺部病變基本吸收。17例亞急性患者均伴明顯的肺部滲出和低氧血癥或呼吸衰竭,明確診斷后除避免環境抗原進一步暴露,酌情予以氧療和對癥支持治療外,給予潑尼松40 mg/d,病情緩解后逐漸減量,療程3~6個月。肺部影像學改變基本吸收,病情未再反復。5例慢性患者中2例使用潑尼松40 mg/d治療,癥狀部分緩解,逐漸減量,療程6~12個月,2例長期口服潑尼松10~15 mg/d維持,病情相對穩定。1例慢性患者急性加重死亡。
二 胸部HRCT特征
24例患者的主要胸部HRCT特征總結見表 1。17例(70.8%)雙肺彌漫分布磨玻璃影,多呈斑片或片狀;15例(62.5%)雙肺彌漫分布細支氣管或小葉中心結節,邊緣模糊;10例(41.7%)氣體陷閉或馬賽克征;5例(20.8%)有網格影或伴蜂窩肺。上述改變常重疊存在,磨玻璃影伴馬賽克征10例,小葉中心結節影伴馬賽克征9例,磨玻璃影、小葉中心結節伴馬賽克征7例,彌漫磨玻璃影伴實變影4例,網格影或伴蜂窩肺伴磨玻璃影2例。2例急性患者分別表現為彌漫磨玻璃影伴實變影(圖 1a、圖 2a),脫離暴露因素并給予甲基潑尼松龍靜滴,后改為潑尼松治療后,3周內病變明顯吸收(圖 1b、圖 2b)。17例亞急性患者中14例(82.4%)為彌漫分布的小葉中心結節(圖 3a、圖 4a),3例(76.5%)為磨玻璃影,8例(47.1%)為馬賽克征,8例(47.1%)為彌漫分布的斑片磨玻璃影伴馬賽克征。脫離暴露因素并給予潑尼松治療后病變均明顯吸收(圖 3b、圖 4b)。5例慢性患者均表現為網格影或伴蜂窩肺(圖 5a),其中2例伴斑片磨玻璃影,1例伴馬賽克征,1例伴小葉中心結節。

三 病理特征
急性期2例行TBLB檢查,病理為肺泡壁和細支氣管壁水腫,以淋巴細胞性肺泡和間質炎癥為主,而嗜酸粒細胞浸潤較少。肺泡腔內有蛋白滲出及炎癥細胞(圖 1c、圖 2c)。亞急性期17例均行TBLB病理檢查,其中11例間質中見非干酪性壞死肉芽腫(圖 3c),其對應的HRCT表現為典型的小葉中心結節,另6例見單核細胞浸潤所致的細支氣管炎(圖 4c)。慢性期5例中有1例開胸肺活檢,病理見纖維化及成纖維細胞灶(圖 5c),其對應的HRCT表現為網格影伴蜂窩肺或牽拉性支氣管擴張(圖 5a)。1例因急性加重死亡,其余3例行BALF檢查。22例(2例急性,17例亞急性,3例慢性)BALF檢查提示肺泡淋巴細胞滲出為主的炎癥,巨噬細胞(31.5±18.3)%,淋巴細胞(36.4±19.7)%,中性粒細胞(22.4±18.5)%,嗜酸粒細胞中位數為2.3%(0.5%~4.5%)。CD4/CD8 T淋巴細胞比值中位數為0.96(0.48~1.61)。

討論
HP多為在工作場所吸入植物或動物的有機粉塵所引起。有機粉塵顆粒通常小于5 μm,反應原進入小氣道和肺泡并進入周圍肺組織,引起肺組織強烈免疫反應和炎癥。目前已經證明可引起HP的抗原物質有200余種,常見的有放線菌、真菌孢子、動植物蛋白質和某些低分子化學物質等。因接觸的抗原的條件和來源不同,本病可有多種不同的疾病名稱,如吸入含嗜熱放線菌(主要為微小多孢子菌,其次為普通嗜熱放線菌)的霉干草粉塵引起的過敏性肺炎稱農民肺(farmer’s lung),吸入含動物蛋白羽毛和排泄物的塵埃引起者稱飼鳥者肺(bird breeder lung),吸入含嗜熱放線菌的蘑菇肥料引起者稱蘑菇工人肺(mushroom worker disease),生活在有嗜熱放線菌污染的空調或濕化器環境引起者稱空調器肺(air conditioner lung)或濕化器肺(humidifier lung)等。
本組24例HP患者均有明確的環境暴露因素,主要暴露因素是寵物飼養或嗜好,以鴿子飼養或嗜好者多見,同時也有其他寵物如鸚鵡、雞、貓、狗飼養或嗜好者,說明寵物嗜好或家庭環境暴露引起的HP是不可忽視的健康問題。此外,化學有機物、藥物、蘑菇種植、真菌孢子也是HP常見的誘因。HP的臨床表現與吸入抗原的量及暴露時間有關,根據初始臨床表現及病程分為急性、亞急性和慢性。急性和亞急性之間存在一定重疊。雖然急性形式是最常見和最具特征的表現形式,但是多數患者癥狀輕微,脫離抗原暴露后自行緩解,很少被診斷。因此,臨床診斷的HP以亞急性和慢性形式為多。本組病例中僅2例表現為急性,絕大多數患者表現為亞急性或慢性。
HP的發病機制尚不完全清楚。目前認為HP最初由Ⅲ型變態反應介導,而后轉向Ⅳ型變態反應為主,而巨噬細胞激活及由此產生的炎癥反應則又可以通過非免疫途徑共同引起肺損傷。此外,接觸有機粉塵的人群中只有少數人發生HP,提示發病者有易感性存在,可能與人類白細胞抗原(HLA)有關,HLA可能是決定遺傳免疫反應的因素,在本病發病中起一定作用。有人認為單獨的侵入抗原可能并不足以引起HP,往往同時存在促發因素,如病毒感染可能導致肺泡巨噬細胞功能改變而促使HP的發生。此外,80%~95%的HP病例發生在非吸煙者,本組吸煙者僅為8.3%,可能與吸煙的免疫抑制效應有關,但吸煙者預后較差,從側面說明吸煙不是罹患HP的危險因素[4-5]。
HP的臨床表現差異較大,取決于接觸抗原的多少、頻繁程度和接觸時間的長短以及宿主的反應性等,可分為急性,亞急性及慢性三種。臨床常見的癥狀為咳嗽、呼吸困難、咳痰、低熱、體重減輕等,而本組最常見的癥狀為呼吸困難。最常見的體征為肺部濕啰音或爆裂音、喘鳴音、輕度發紺、杵狀指等。本組肺功能檢查顯示患者幾乎均有彌散功能障礙,其中大部分有限制性通氣功能障礙和小氣道功能障礙,與文獻報道一致[6]。血氣分析也顯示大部分有低氧血癥或Ⅰ型呼吸衰竭。
本組HP患者胸部HRCT的主要特征為磨玻璃影、小葉中心結節、馬賽克征、網格影或蜂窩肺,與文獻報道一致[6-11]。這些HRCT改變在不同臨床表現形式的出現頻率不同,而且經常是幾種表現同時出現。急性主要表現為彌漫磨玻璃影伴實變影;亞急性主要表現為雙肺彌漫分布的小葉中心結節、馬賽克征和斑片磨玻璃影伴馬賽克征;慢性主要表現網格影或伴蜂窩肺,小葉間隔增厚或牽拉性細支氣管擴張。這些特征與HP的不同臨床表現形式有關,掌握這些特點對于HP的診斷有重要幫助。據胸部HRCT的特征,結合環境抗原暴露史、相應的臨床表現、BALF提示淋巴細胞為主的肺部滲出及TBLB病理,通常可以做出診斷。僅少部分慢性HP患者由于TBLB所取的肺組織不能代表全肺的病變情況,需要外科肺活檢行病理檢查幫助確定診斷。
HP雖然病原很多,但在組織學上的改變非常近似,多數不能從組織形態學上鑒別,病理學特征取決于抗原暴露的程度及活檢時病程所處的階段。急性期病理表現為肺泡壁和細支氣管壁水腫,以淋巴細胞性肺泡和間質炎癥為主,肺泡腔內有蛋白滲出及炎癥細胞。亞急性期的特征性改變是非干酪樣壞死性肉芽腫形成,和/或單核細胞浸潤所致的細支氣管炎。肺肉芽腫常在發病3周內出現,在1年內緩慢消散,用糖皮質激素可促進其吸收。慢性期以肺間質纖維化為主,尤其在細支氣管和所屬小動脈有時因肌纖維和內皮細胞增生而增厚,而肉芽腫病變此時基本消失。由于纖維化的牽拉和收縮,肺組織結構破壞,可發展為肺氣腫乃至蜂窩肺。本組急性及亞急性HP均行TBLB病理檢查,一部分見非壞死性肉芽腫,一部分為淋巴細胞性細支氣管炎,基本得以病理診斷,這與我們TBLB所取的肺組織大部分在0.2 cm以上且為多部位獲取組織有關。患者BALF細胞學檢查均顯示淋巴細胞明顯增加。本組慢性HP患者的診斷主要依據相關抗原的暴露、影像學、BALF的細胞學改變。對于胸部HRCT顯示的網格影或伴蜂窩肺或牽拉性細支氣管擴張的患者,TBLB的病理診斷意義有限,最好行外科肺活檢。但本組5例慢性HP患者除1例急性加重死亡外,1例行外科肺活檢,其余3例行BALF檢查。文獻報道慢性HP組織學顯示UIP樣改變或纖維化型NSIP樣改變的HP起病隱匿,預后差,而組織學呈閉塞性細支氣管炎伴機化性肺炎或細胞型NSIP樣改變的HP多易反復發作,但預后好[12-13]。胸部HRCT特征在一定程度上可以間接反映HP的組織病理類型,可能對預后有一定的提示作用。
綜上所述,臨床上HP是少見病,診斷困難,經常漏診或誤診,造成病情遷延不愈,呈慢性化發展而影響預后。對于急性及亞急性HP病例,我們應根據其臨床特征,包括相關抗原的暴露、影像學、BALF的細胞學改變及TBLB病理作出診斷。對于慢性的HP病例,尤其是暴露因素不典型時,要有足夠的識別能力,TBLB所取的組織不足以代表全肺的病變狀態,必要時進行外科肺活檢而做出臨床-影像學-病理的綜合診斷。